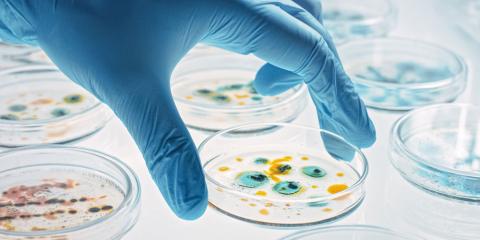
Gloved hand holding a petri dish with blue and yellow cells

Human health throughout the lifespan is one of the cornerstone research areas at RPI. Our world-class team of researchers investigates topics ranging from neurodevelopment to neurodegenerative conditions, cancer detection and treatments, biomaterials and tissues that can be used for replacements, understanding the effect of circadian rhythms on human health, as well as inventing and producing the next generation of drugs.
Faculty



Professor and Technology Manager, CESMII Northern Regional Manufacturing Center




Institute Professor, Chemical and Biological Engineering, Member National Academy of Engineering, Vice President, Office of Strategic Alliances and Translation






Dorothy and Fred Chau ʼ71 Career Development Constellation Professor in Biocatalysis and Metabolic Engineering









Yamada Corporation Professor and RPI Co-Director, Center for Engineering and Precision Medicine (CEPM)



Clark & Crossan Endowed Chair Professor, Director of Biomedical Imaging Center, Editor-in-Chief of IEEE Trans. Medical Imaging


